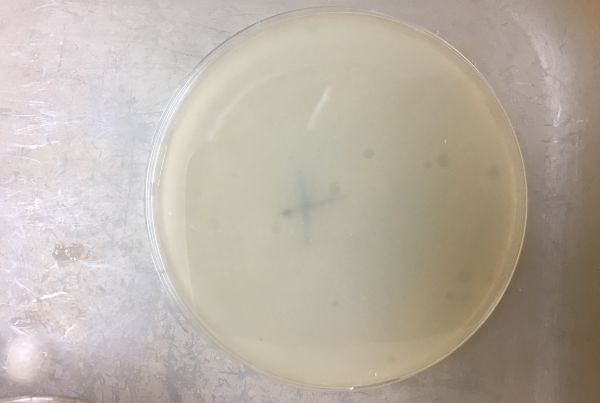
MSC plate

Fecal coliform testing
The main analysis in the Bureau lab is fecal coliform testing in seawater and shellfish tissue samples.
Fecal coliform bacteria have a high association with fecal matter from warm-blooded animals. Human sewage contains potentially pathogenic bacteria, viruses, and parasites. Fecal coliforms are readily and inexpensively analyzed in the lab, and have been selected by the U.S. Food and Drug Administration (FDA) as an indicator organism suitable for the evaluation of the sanitary condition of seawater.
DoAg collects data to demonstrate that fecal coliform levels in water and shellfish tissue samples are correlated and acceptable.